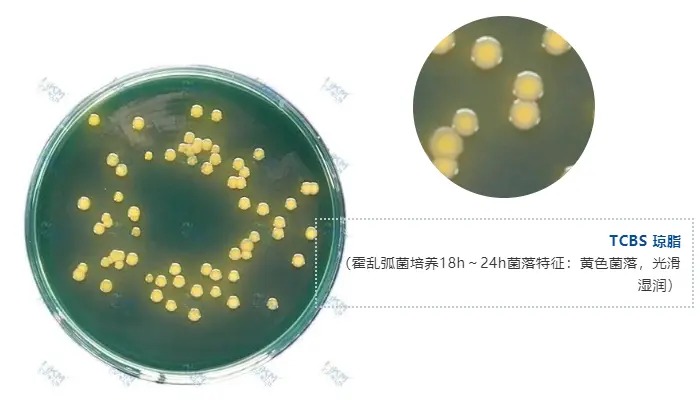
TCBS 琼脂（霍乱弧菌培养18h～24h菌落特征：黄色菌落，光滑湿润）
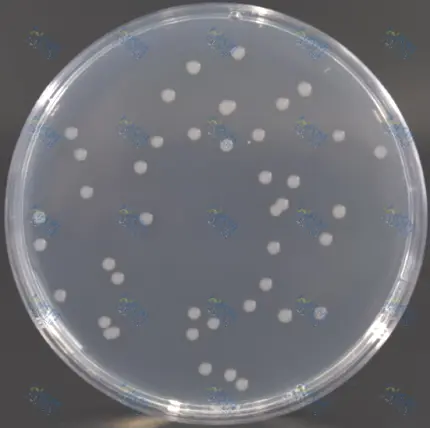
霍乱弧菌培养18h～24h特征
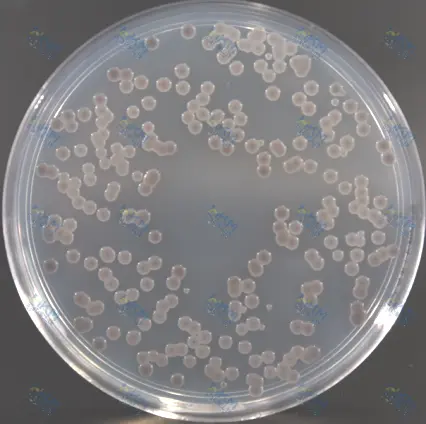
霍乱弧菌培养36h～48h特征

什么是霍乱?怎么检测?如何预防?
发布时间:2022-07-19 浏览次数:2672
近日武汉一例霍乱确诊病例引起社会的广泛关注,“霍乱”一词迅登顶热搜。因为在很多人的印象里,霍乱是一种古老且遥远的疾病。但实际上在全球范围内,霍乱的威胁一直存在。
一 什么是霍乱弧菌
霍乱是由霍乱弧菌(V.cholerae)引起烈性传染病,主要通过食用被污染的水和食物传播。霍乱弧菌广泛存在于自然界江河湖海等水体中,有超过200种血清群,其中O1和O139血清群能引起霍乱。霍乱发病急、传播快、波及范围广、能引起世界大流行,是《国际卫生条例》规定的国际检疫传染病之一,也是《中华人民共和国传染病防治法》规定的甲类传染病。

二 如何流行传播及预防?
霍乱是经口感染的肠道传染病。常经水、食物、生活接触和苍蝇等传播。人类对本病普遍易感。在我国,霍乱流行以沿海地区为主,特别是江河入海口附近的江河两岸及水网地带,多数地区发病季节一般在5—10月,而流行高峰在7—10月。
对阻断霍乱的流行传播,主要以防为主,做好对外交往及入口的检疫工作,严防本菌传入,此外应加强水、粪管理,注意饮食卫生。对病人要严格隔离,必要时实行疫区封锁,以免疾病扩散蔓延。

三 霍乱弧菌的生物学特性
霍乱弧菌为革兰染色阴性,菌体呈弧形或逗点状,无芽孢,无荚膜,菌体单端有一根鞭毛,运动极为活跃,在暗视野显微镜下观察呈穿梭状运动。患者粪便直接涂片镜检,常可见弧菌相互衔接,排列呈“鱼群”状。

四 霍乱弧菌检测
目前,国内对于霍乱弧菌检测的方法标准:《霍乱防治手册(第六版)》和《霍乱诊断标准 WS289-2008》适用于全国各级各类医疗卫生机构对霍乱病例及带菌者的检测诊断,《SN/T 1022-2010 进出口食品中霍乱弧菌检验方法》适用于动物饲料和其他食品以及生产加工区域环境样品霍乱弧菌检验。

在霍乱弧菌检测中分离培养基的选择非常关键!!!
霍乱弧菌的选择性分离培养基有强、弱之分,强选择性的分离培养基主要包括 TCBS 琼脂、庆大霉素琼脂、4 号琼脂等;弱选择性分离培养基主要是碱性琼脂、碱性胆盐琼脂。
虽然TCBS 是 WHO 推荐并在全球应用较为广泛的分离霍乱弧菌、副溶血弧菌的强选择性培养基,但其他的蔗糖发酵菌会影响TCBS琼脂上霍乱弧菌的鉴定,影响检测结果。
TCBS琼脂(霍乱弧菌培养18h~24h菌落特征:黄色菌落,光滑湿润)
培养18h~24h |
培养36h~48h |
庆大霉素琼脂(霍乱弧菌菌落特征:带灰色的半透明为主;随着培养时间的延长,灰色现象越明显,可出现菌落中央明显的灰黑色,而边缘呈略带灰色的半透明状)
注:四号琼脂菌落生长特征与庆大霉素琼脂基本类似。
为了能更好、更快、更有效地应对各种突发事件,环凯微生物已研发出以霍乱弧菌特异性酶作为筛选靶标的霍乱弧菌显色培养基(货号:CRM009),目前产品广泛应用于食品安全、疾病防控、海水环境监测等领域。
CRM009霍乱弧菌显色培养基特点:
促进霍乱弧菌生长,培养18小时菌落特征颜色清晰,结果一目了然;
选择性强,杂菌干扰少,有利于目标菌检出,大大减少后续确证工作量;
适用于水产品及食物中毒样品中霍乱弧菌的快速分离和鉴定。

CRM009霍乱弧菌显色培养基(霍乱弧菌菌落特征:绿-蓝色菌落)
环凯微生物提供的霍乱弧菌检测成套产品解决方案